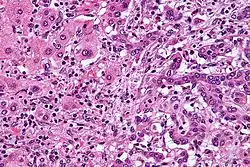

سرطانة الأقنية الصفراوية
سرطانة الأقنية الصفراوية (1) هو نوعٌ من السرطان المُتكون في الأقنية الصفراوية.[1] ينتجٌ عنه عددٌ من الأعراض والتي قد تشمل ألمًا بطنيًا واصفرارًا جلديًا وفقدانًا في الوزن وحكةً عامة وحمى،[3] كما قد يُصبح البُراز فاتحًا أو يُصبح البول غامقًا في اللون.[4] تُوجد سرطاناتٌ أُخرى في الجهاز الصفراوي وتشمل سرطان الحويصلة الصفراوية وسرطان أمبولة فاتر.[7]
| سرطانة الأقنية الصفراوية | |
|---|---|
| (الاسم العلمي: Cholangiocarcinoma) | |
![]() صورة مجهرية لسرطانة الأقنية الصفراوية داخل الكبد (يمين) بالقرب من خلايًا كبدية طبيعية (يسار). (باستعمال صبغة الهيماتوكسيلين واليوزين) صورة مجهرية لسرطانة الأقنية الصفراوية داخل الكبد (يمين) بالقرب من خلايًا كبدية طبيعية (يسار). (باستعمال صبغة الهيماتوكسيلين واليوزين) | |
| تسميات أخرى | سرطانة الأوعية الصفراوية، سرطانة قنوية صفراوية، سرطان وعائي صفراوي |
| النطق | بالإنجليزية: koh-LAN-jee-oh-KAR-sih-NOH-muh[1] |
| معلومات عامة | |
| الاختصاص | علم الأورام |
| الأسباب | |
| الأسباب | داخل الكبد، محيط بنقير الكبد، قاصِ[2] |
| عوامل الخطر | التهاب الأقنية الصفراوية المصلب الابتدائي، والتهاب القولون التقرحي، وتشمع الكبد، والتهاب الكبد ج، والتهاب الكبد ب، بالإضافة إلى العدوى ببعض مثقبيات الكبد وبعض تشوهاتِ الكبد الخلقية.[3] |
| المظهر السريري | |
| البداية المعتادة | عمر 70 عامًا[2] |
| الأعراض | ألم بطني، اصفرار جلدي، فقدان الوزن، حكة عامة، حمى[3] |
| الإدارة | |
| التشخيص | يؤكد حدوث سرطانة الأقنية الصفراوية عبر الفحص المجهري لخلايًا مؤخذةٍ من الورم.[4] |
| العلاج | قطعٌ جراحي، والعلاج الكيميائي، والعلاج بالأشعة والدعامات، وزراعة الكبد.[3] |
| أدوية | |
| المآل | عادةً سيء[5] |
| الوبائيات | |
| انتشار المرض | 1-2 حالة لكل 100,000 شخص سنويًا في العالم الغربي.[6] |
هناك عددٌ من عوامل خطر حدوث سرطانة الأقنية الصفراوية، وتتضمن التهاب الأقنية الصفراوية المصلب الابتدائي، والتهاب القولون التقرحي، وتشمع الكبد، والتهاب الكبد ج، والتهاب الكبد ب، بالإضافة إلى العدوى ببعض مثقبيات الكبد وبعض تشوهاتِ الكبد الخلقية.[2][3][8] على الرغم من هذا، إلا أنَّ معظم الأشخاص لا يُوجد لديهم عوامل خطرٍ محددة.[2] يشتبه بتَشخيص سرطانة الأقنية الصفراوية اعتمادًا على تحليلات الدم، والتصوير الطبي، والتنظير الداخلي، وفي بعض الأحيان تُجرى جراحةٌ استكشافية.[4] يؤكد حدوث سرطانة الأقنية الصفراوية عبر الفحص المجهري لخلايًا مؤخذةٍ من الورم.[4] عادةً ما تُعتبر سرطانة الأقنية الصفراوية سرطانةً غدية (سرطان يُكونُ غددًا أو يُفرز الموسين).[2]
عادةً عند تشخيص سرطانة الأقنية الصفراوية تكون قد وصلت لمرحلةٍ غيرِ قابلةٍ للشفاء،[3] وفي هذه الحالات فإنَّ الرعاية التلطيفية قد تتضمن إجراء قطعٍ جراحي والعلاج الكيميائي والعلاج بالأشعة والدعامات.[3] في حوالي ثلث الحالات التي تكون فيها السرطانة في القناة الصفراوية المشتركة فإنهُ يُمكن إزالة الورم كاملًا عن طريق الجراحة مما يمنح الشخص فرصةً في الشفاء، وهذا الإجراء أقل شيوعًا في مواقع السرطانة الأُخرى.[3] حتى لو كانت الإزالة الجراحية ناجحةً إلا أنهُ يُوصى بإجراء العلاج الكيميائي والعلاج بالأشعة.[3] في بعض الحالات قد تُجرى زراعةٌ للكبد.[2] عادةً ما يكون معدل النجاة لخمس سنواتٍ أقل من 50% حتى لو كانت الجراحة ناجحةً.[6]
من النادر حدوث سرطانة الأقنية الصفراوية في العالم الغربي، ويكون مُعدل حدوثها 0.5-2 حالة لكل 100,00 شخص سنويًا،[3][6] وتكون المُعدلات أعلى في جنوب شرق آسيا حيثُ تنتشر هُناك مثقبيات الكبد.[5] تصلُ مُعدلات السرطانة في مناطق من تايلاند إلى 60 حالة لكل 100,000 شخص سنويًا،[5] وتُعتبر من أكثر أنواع السرطانات انتشارًا في تايلاند خاصةً في الجزء الشمالي الشرقي.[9] عادةً ما تحدث سرطانة الأقنية الصفراوية في العقد الثامن من حياة الأفراد، ولكن عادةً ما تحدث في العقد الخامس في الأشخاص المُصابين بالتهاب الأقنية الصفراوية المصلب الابتدائي.[2] تزداد مُعدلات حدوث سرطانة الأقنية الصفراوية في الكبد في العالم الغربي.[6]
التسمية
1 سَرَطانَة الأَقْنِيَة الصَّفْراوِيَّة[10][11][12] (بالإنجليزية: Cholangiocarcinoma) (اختصارًا CCA) وتسمى أيضًا:
- سرطانة الأوعية الصفراوية.[10][11]
- سرطانة القنوات الصفراوية.[13]
- سرطانة قنوية صفراوية.[14]
- سرطان وعائي صفراوي.[10]
يتكون المُصطلح الإنجليزي (Cholangiocarcinoma) من مقطعين:
- -Cholangio وهي بادئة تعني القناة الصفراوية
- carcinoma- وهي لاحقة تعني سرطانة، وهي تصنيفٌ لأنواع السرطان التي تحدث في الخلايا الطلائية.[15]
العلامات والأعراض
من الشائع حدوث بعض الأعراض مع سرطانة الأقنية الصفراوية والتي تتضمن اضطرابًا في اختبارات وظائف الكبد، ويرقان (اصفرارٌ في العيون والجلد، يحدث بسبب انسداد الأقنية الصفراوية بالورم)، وألم بطني (30–50%)، وحكةٌ عامة (66%)، وفقدان الوزن (30–50%)، وحمى (حوالي 20%)، وتغيراتٍ في لون البول أو البراز البشري بسبب قلةِ طرح العصارة الصفراوية في القناة الهضمية.[16][17]
عادةً ما تعتمدُ أعراض السرطانة على موقعها التشريحي، فالأشخاص المُصابون بالسرطانة في الأقنية الصفراوية خارج الكبد يكونون أكثر عرضةً لحدوث اليرقان، أما المُصابون بالسرطانة في الأقنية الصفراوية داخل الكبد فهم أكثرُ عرضةً للألم في الجانب الأيمن من البطن دون حدوث اليرقان أو تغير لونِ البراز.[18]
عادةً تُظهر الاختبارات الدموية لوظائف الكبد في الأشخاص المُصابين بسرطانة الأقنية الصفراوية مظهرًا يُسمى "النمط الانسدادي"، والذي يتضمن ارتفاعًا في مستويات البيليروبين، والفوسفاتاز القلوي (AP)، وناقلة الببتيد غاما غلوتاميل (GGT)، مع مستوياتٍ طبيعية نسبيًا في ناقلة الأمين (ALT وASAT)، حيثُ تُساعد هذه النتائج المخبرية في توقع حدوث انسدادٍ في الأقنية الصفراوية وليس التهاب أو عدوى في النسيج الحشوي للكبد، وبالتالي معرفة السبب الأساسي لحدوث اليرقان.[19] يحدثُ في مُعظم الحالات ارتفاعٌ في مستويات الواسمات الورمية في الدم، مثل CA19-9.[20]
عوامل الخطر
حُددت العديد من عوامل خطر حدوث سرطانة الأقنية الصفراوية، وذلك على الرغم أنَّ مُعظم الأشخاص يُصابون دون وجود أي عوامل خطر. يُعتبر التهاب الأقنية الصفراوية المصلب الابتدائي (PSC) أكثر عوامل الخطر شيوعًا في العالم الغربي، وهو مرضٌ التهابي يُصيب الأقنية الصفراوية، ويرتبط عادةً مع التهاب القولون التقرحي (UC).[21] أشارت دراساتٌ وبائية أنَّ خطر الإصابة بسرطانة الأقنية الصفراوية طوال حياة شخصٍ مُصابٍ بالتهاب الأقنية الصفراوية المصلب الابتدائي يتراوح ما بين 10-15%،[22] وذلك على الرغم أنَّ عدة دراساتٍ تشريحية أظهرت معدلاتٍ تصل إلى 30% لدى هذه الفئة من الأشخاص.[23]

تُعتبر بعضُ أمراض الكبد الطفيلية من عوامل الخطر أيضًا، فقد وُجدَ أنَّ بعض الأمراض الطفيلية ترتبطُ بحدوث سرطانة الأقنية الصفراوية وتتضمن مثقبيات الكبد متأخرة الخصية الزبادي (تُوجد في تايلاند ولاوس والفيتنام)[24][25][26] ومتفرع الخصية الصيني (يُوجد في الصين وتايوان وشرق روسيا وكوريا والفيتنام)[27][28]، حيثُ في عام 2009 سُلطَ الضوءُ على التأثير السرطاني لهذه الطفيليات، وكان ذلك عند اكتشاف Ov-GRN-1 غرانيولن، وهو عامل نمو تُنتجه هذه الطفيليات ولديه القُدرة على تحفيز تكاثر خلايا المُضيف.[29] وجدَ أنَّ برامجُ المكافحة التي تهدفُ إلى عدم تشجيع استهلاك الأطعمة النيئة وغير المطهية جيدًا قد نجحت في الحدِ من الإصابة بسرطانة الأقنية الصفراوية في بعض البلدان.[30] تزدادُ احتمالية الإصابة بسرطانة الأقنية الصفراوية بشكلٍ ملحوظ في الأشخاص المُصابين بأمراضٍ كبديةٍ مُزمنة، سواءً كانت فيروسية (مثل التهاب الكبد ب أو التهاب الكبد سي)،[31][32][33] أو مرض الكبد الكحولي أو تشمع الكبد بسبب أسبابٍ أُخرى.[34][35] وضعت دراسةٌ واحدةٌ العدوى بفيروس نقص المناعة البشري (HIV) كعاملِ خطرٍ مُحتمل لحدوث السرطانة، ولكنهُ من غير المعروف فيما إذا كان الفيروس نفسه يُسبب السرطانة أو عوامل أُخرى مُرتبطة (مثل العدوى بالتهاب الكبد سي).[34] قد تؤدي العدوى بالبكتيريا الملوية الصفراء والملوية الكبدية إلى حدوثِ سرطان الأقنية الصفراوية.[36]
ترتبطُ بعض اضطرابات الكبد الخلقية مع خطرٍ بحوالي 15% لحدوث سرطانة الأقنية الصفراوية في حياة الشخص، ومنها متلازمة كارولي (نوعٌ خاص من الخمسةِ أنواعٍ المعروفة من كيسات الأقنية الصفراوية).[37][38] وجد أيضًا ارتباطٌ بعض الاضطرابات الوراثية النادرة مع سرطانة الأقنية الصفراوية، خصوصًا النوع الثاني من متلازمة لينش والورام الحليمي الصفراوي.[39][40] من غير الواضح فيما إذا كان وجود الحصوات الصفراوية يرتبطٌ مع السرطانة، ولكن الحصوات داخل الكبد (تُعرف بتحصِ الكبد، وهي نادرةٌ في العالم الغربي ولكن شائعةٌ في أجزاءٍ من آسيا) ترتبط بشدةٍ مع سرطانة الأقنية الصفراوية.[41][42][43] يرتبط التعرض للديوكسين[44] وللثوروتراست (شكلٌ من ثاني أكسيد الثوريوم، يُستعمل كمادةٍ مُظللة) مع حدوث سرطانة الأقنية الصفراوية في مرحلةٍ مُتاخرةٍ تصلُ إلى 30-40 عامًا بعد التعرض لها، ويُذكر أن الثوروتراست حُظرت في الولايات المتحدة الأمريكية في عقد 1950 لاعتباره مادة مُسرطنة.[45][46][47]
الفيزيولوجيا المرضية

قد تُؤثر سرطانة الأقنية الصفراوية على أي جزءٍ من الأقنية الصفراوية، سواءً كانت داخل أو خارج الكبد، وتُقسم السرطانة عمومًا إلى داخل الكبد (intrahepatic) أو خارج الكبد (extrahepatic) أو محيطٌ بالنقير (perihilar)، أما سرطانة الأقنية الصفراوية التي تحدث في نقطة التقاء الأقنية الكبدية اليُمنى واليسرى لتكوين القناة الكبدية المشتركة فتُعرف باسم ورم كلاتسكين.[48]
تمتلكُ سرطانة الأقنية الصفراوية نفس السمات النسيجية والجزيئية للسرطانة الغدية في الخلايا الظهارية المُبطنة للجهاز الصفراوي، ولكن على الرغم من هذا، إلا أنَّ خلية المنشأ الحقيقية لا تزال مجهولةً. اقترحت أدلةٌ حديثة أنَّ الخلية المتحولة الأولية التي ينشأ عنها الورم الأولي قد تنشأ من خليةٍ جذعيةٍ كبديةٍ متعددة القدرات.[49][50][51] يُعتقد أنَّ سرطانة الأقنية الصفراوية تحدث في سلسلةٍ من المراحل (من فرط التنسج والتحول النسيجي المُبكر إلى خلل التنسج، ثُم حدوث سرطانةٍ واضحة) في عمليةٍ مشابهة لتلك التي تحدث في سرطان القولون،[52] كما يُعتقد أيضًا أنَّ الالتهاب المُزمن والانسداد في الأقنية الصفراوية، وما ينتجُ عنه من ضعفٍ في تدفق الصفراء، يلعبُ دورًا في تقدم وتطور المرض.[52][53][54] هُناك فرضيةٌ أُخرى مرتبطةٌ بالغشاء الحيوي الرقيق الذي تُشكله السلمونيلا التيفية بشكلٍ خاص.[55][56][57]
قد تتنوع سرطانة الأقنية الصفراوية نسيجيًا من لامتمايزةٍ إلى جيدة التمايز. غالبًا ما تكون مُحاطةً باستجابةٍ نسيجية نشطةٍ تليفيةٍ أو مكونةٍ للنسيج الليفي، وفي حال وجود تليفٍ بارز، فإنه قد يصعبُ تمييز سرطانة الأقنية الصفراوية جيدة التمايز عن النسيج الطلائي التفاعلي الطبيعي. لا تُوجد صبغةٌ كيميائية نسيجية مناعية خاصةٌ لتمييز النسيج القنوي الصفراوي الخبيث عن الحميد، ولكن على الرغم من هذا، إلاأنَّ صبغ الكيراتين الخلوي والمستضد السرطاني المضغي والموسين قد تُساعد على التشخيص.[58] مُعظم سرطانات الأقنية الصفراوية (>90%) هي سرطانات غدية.[59]
التشخيص

يُؤَكَد تشخيص سرطانة الأقنية الصفراوية فقط بالفحص النسيجي، حيثُ تؤخذ خزعةٌ ورمية خلال أو بعد الإجراء الجراحي، كما أنه يُمكن الاشتباه بحدوث السرطانة في المرضى الذين يظهر لديهم يرقانُ بيليروبين مقترن يَسُدُ الأقنية الصفراوية، ولكن يصعُب استعماله كأداةٍ تشخيصية في المرضى المُصابين بالتهاب الأقنية الصفراوية المصلب الابتدائي، كونهم مُعرضون لخطرٍ عالٍ لحدوث سرطانة الأقنية الصفراوية، كما أنه يصعب التمييز بين الأعراض في مثل هذه الحالات، وأيضًا قد لا يكون التصوير التشخصيي الطبي واضحًا. قد تُساعد بروتيوميات الأنسجة والمصل الدموي، بالإضافة إلى تقنية التفاظ الليزر بمساعدة المطرس (MALDI) على تحديد واسماتٍ حيوية مُحتملة خاصة بسرطانة الأقنية الصفراوية، مما يُحسن من تشخيصها.[60]
فحوصات الدم
لا يُوجد فحصٌ دموي خاصٌ لتشخيص سرطانة الأقنية الصفراوية، ولكن عادةً يحدث ارتفاعٌ في المستضد السرطاني المضغي (CEA) وفي CA19-9، ولكنها غيرُ حساسةٍ أو نوعيةٍ بشكلٍ كافٍ لاستعمالها كأداةٍ في الكشف الطبي، ولكنها قد تكونُ مفيدةً إذا اقترنت أيضًا مع نتائج التصوير التشخيصي الطبي التي تشتبه بحدوث سرطانة الأقنية الصفرواية.[20]
التصوير البطني

عادةً ما يُستعمل التصوير بالموجات فوق الصوتية للكبد والجهاز الصفراوي كأداةٍ تصويرية أولية في الأشخاص المُحتمل إصابتهم بيرقانٍ انسدادي،[61][62] حيثُ قد يُساعد التصوير بالموجات فوق الصوتية على تحديد الانسداد والتوسع القنوي، كما قد يكون كافيًا في بعض الحالات لتشخيص سرطانة الأقنية الصفراوية.[63] قد يُستعمل التنظير بالموجات فوق الصوتية في إزالة السليلات الصغيرة قبل أن تتحول إلى سرطانة.[64][65] قد يلعبُ التصوير المقطعي المحوسب دورًا مهمًا في تشخيص سرطانة الأقنية الصفراوية،[66][67][68] ولكنهُ قد لا يُظهر بوضوح انتشار السرطانة في الأقنية الصفراوية.[69]
تصوير الجهاز الصفراوي

على الرغم من أنَّ التصوير البطني قد يكون كافيًا في تشخيص سرطانة الأقنية الصفراوية، إلا أنَّ التصوير المُباشر للأقنية الصفراوية يكون عادةً ضروريًا، ويعتبر تصوير البنكرياس والأقنية الصفراوية بالتنظير الباطني بالطريق الراجع (ERCP) من أكثر الإجراءات استعمالًا لهذا الغرض، وهو إجراءٌ تنظيري داخلي، يُجريه أخصائيُ الجهاز الهضمي أو جراحٌ خاصٌ مُتمَرس. على الرغم من أنَّ تصوير البنكرياس والأقنية الصفراوية بالتنظير الباطني بالطريق الراجع يُعتبر إجراءًا جراحيًا مُتوغل يتضمن أخطارًا مُصاحبة، إلا أنَّ مزاياهُ متعددة وتشمل القُدرة على الحصول خزعاتٍ، بالإضافة إلى وضع دعاماتٍ أو إجراء تدخلاتٍ أُخرى للتخفيف من انسداد الأقنية الصفراوية.[19]
يُمكن إجراءُ تنظيرٍ بالموجات فوق الصوتية في نفس وقت تصوير البنكرياس والأقنية الصفراوية بالتنظير الباطني بالطريق الراجع، مما قد يزيدُ من دقةِ الخزعة، وإعطاء معلوماتٍ حول مدى الانتشار إلى العقد اللمفاوية ومدى قابلية السرطانة للجراحة.[70] يُمكن استخدام تصوير الأقنية الصفراوية عبر الكبد عن طريق الجلد (PTC) بدلًا من تصوير البنكرياس والأقنية الصفراوية بالتنظير الباطني بالطريق الراجع. يُعتبر تصوير البنكرياس والأقنية الصفراوية بالرنين المغناطيسي (MRCP) البديل غير المُتوغل لتصوير البنكرياس والأقنية الصفراوية بالتنظير الباطني بالطريق الراجع.[71][72][73] اقترح البعض أنَّ تصوير البنكرياس والأقنية الصفراوية بالرنين المغناطيسي يجب أن يحل مَحل تصوير البنكرياس والأقنية الصفراوية بالتنظير الباطني بالطريق الراجع في تشخيص السرطانات الصفراوية؛ وذلك لأنهُ قد يحدد الورم بدقةٍ أكبر مع تجنب المخاطر المصاحبة لتصوير البنكرياس والأقنية الصفراوية بالتنظير الباطني بالطريق الراجع.[74][75][76]
الجراحة
قد يكون إجراءُ جراحةٍ استكشافية ضروريًا للحصول على خزعة مُناسبة، ومن ثُم تحديد مرحلة التطور الدقيقة في الشخص المُصاب بسرطانة الأقنية الصفراوية. يُمكن أيضًا استعمال تنظير البطن لأغراض تحديد مرحلة السرطانة، مما يُساعد في تجنب استعمال الإجراءات الجراحية المتوغلة مثل فتح البطن في بعض الأشخاص.[77][78]
علم الأمراض النسيجي
حسب علم الأمراض النسيجي، فإنَّ سرطانات الأقنية الصفراوية هي سرطاناتٌ غدية جيدةٌ إلى متوسطةِ التمايز. الكيمياء النسيجية المناعية مفيدةٌ في التشخيص، وقد تستخدم لتفرقة سرطانة الأقنية الصفراوية عن سرطانة الخلية الكبدية والانبثاثات الناتجة عن الأورام المَعِدية المعوية الأُخرى.[79] عادةً لا تُساعد العينات الخلوية في التشخيص؛[80] وذلك لأنَّ هذه الأورام تمتلك لٌحمةً مثاليةً مكونةً للنسيج الليفي، وبالتالي لا تُظهر أيَّ خلايًا ورمية مميزة في العينات، ولكن على الرغم من هذا إلا أنَّ إنتغرين Αvβ6 يُعتبر واسمًا جيدًا (النوعية 100%، الحساسية 86%، وأفضل من CK7 وCK20 وHepPar1) لتشخيص سرطانة الأقنية الصفراوية، مقارنةً مع سرطانة الخلية الكبدية والسرطانات الأُخرى.[81]
مراحل التطور

على الرغم من وجود ثلاثة أنظمةٍ على الأقل لتصنيف مراحل تطور السرطانة (مثل أنظمة بزموث، وبلومجارت، واللجنة الأمريكية المشتركة للسرطان)، إلا أنَّ جميعها غير مُفيدةٍ في التنبؤ بمدة البقاء على قيد الحياة.[82] إنَّ أهمَ مشكلةٍ تواجه أنظمة تصنيف المراحل، هي تحديد فيما إذا كان الورم قابلًا للاستئصال الجراحي أو فيما إذا كان قد وصل إلى مرحلةٍ مُتقدمةٍ جدًا، وبالتالي لن ينجح العلاج الجراحي. عادةً لا يُمكن تحديد ذلك إلا أثناء الجراحة.[19]
تُوجد إرشاداتٌ عامة حول الأورام القابلة للجراحة، حيثُ تتضمن:[83][84]
- عدم وجود انبثاثاتٍ (انتشاراتٍ) في الكبد أو العُقدة اللمفاوية.
- عدم اشتراك الوريد البابي في الورم.
- عدم وجود توغلٍ مباشر للأعضاء القريبة.
- عدم وجود مرضٍ منتشرٍ بشكلٍ واسع.
وجدت عدة دراساتٌ في عام 2009، أنَّ نسبة النجاة لمدة خمس سنواتٍ بلغت حوالي 20% في المرضى المُعالجين جراحيًا،[85] أما في دراسةٍ أُخرى عام 2007 فكانت النسبة 32%.[86]
العلاج
تُعتبر سرطانة الأقنية الصفراوية مرضًا غيرُ قابلٍ للشفاء وتُسبب الوفاة سريعًا إذا لم تستئصل جراحيًا وبشكلٍ كُلي. لا يُمكن تحديد قابلية السرطانة للاستئصال إلا أثناء العملية الجراحية في مُعظم الحالات،[87] لذلك يخضعُ غالبية الأشخاص إلى جراحةٍ استكشافية مالم يكن هُنالك دليلٌ واضحٌ على أنَّ السرطانة غير قابلةٍ للاستئصال.[19] سجلت مايو كلينك نجاحًا كبيرًا في علاج سرطانة الأقنية الصفراوية المُبكرة عبر زراعة الكبد باستخدام نهجٍ مُنظم مع معايير اختيارٍ صارمة.[88]
العلاج الكيميائي والإشعاعي المساند
إذا كان الورم قابلًا للإزالة جراحيًا، فإنَّ الأشخاص قد يتلقون علاجًا كيميائيًا وإشعاعيًا مساندًا بعد العملية؛ وذلك بهدف تحسين فُرص الشفاء. لا تُوجد فائدةٌ للعلاجِ المُساند إذا استُئصِل الورم كُليًا (تكون الحواف النسيجية للورم سلبيةً)، كما وُثقت نتائجُ إيجابية[89][90] وسلبية[18][91][92] مع العلاج الإشعاعي المساند في سرطانة الأقنية الصفراوية، ولم تُجرَ أيُ تجارب منضبطة معشاة منذ مارس 2007. يُعتبر العلاج الكيميائي المُساند غير فعالٍ في الأشخاص الذين قطع الورم لديهم كليًا،[93] كما أنَّ دور العلاج الكيميائي الإشعاعي في هذه الحالات لا يزال غير واضحٍ. إذا كانت الحواف النسيجية للورم إيجابيةً، فهذا يُشير إلى أنَّ الورم لم يُستئصل كليًا في الجراحة، وبالتالي يُوصى عمومًا واستنادًا إلى البيانات المتاحة، باستعمال العلاج الإشعاعي المساند وُربما أيضًا استعمال العلاج الكيميائي المُساند.[94]
علاج الحالات المتقدمة

تكونُ معظم حالات سرطانة الأقنية الصفراوية غير قابلةٍ للقطع الجراحي،[95] وتعالج هذه الحالات عمومًا بالعلاج التلطيفي الكيميائي مع أو دون العلاج الإشعاعي. أظهرت تجربة منضبطة معشاة بأنَّ العلاج الكيميائي يلعبُ دورًا في تحسين جودة حياة المريض، بالإضافة إلى إطالة فترة البقاء على قيد الحياة في الأشخاص المُصابين بسرطانة الأقنية الصفراوية غير القابلة للجراحة.[96] لا يوجد نظامٌ علاجيٌ كيميائي مُوحدٌ عالميًا، وغالبًا ما يوصى بالالتحاق بالتجارب السريرية إذا كان ذلك ممكنًا.[94] يُوجد عددٌ من المواد المستعملة في العلاج الكيميائي لسرطانة الأقنية الصفراوية، وتشمل 5-فلورويوراسيل مع لوكوفورين،[97] أو جيمسيتابين لوحده،[98] أو جيمسيتابين مع سيسبلاتين[99] أو إرينوتيكان[100] أو كابسيتابين.[101]
زراعة الكبد
بقيت زراعة الكبد خلافيةً لفترةٍ طويلةٍ من الزمن، وذلك لأنَّ الدراسات الأولية أظهرت إعادة حدوث سرطانة الأقنية الصفراوية بنسبة 100% بعد زراعة الكبد، ولكن أظهرت تقاريرٌ مُتعددة من فرقٍ جراحية بأنَّ معدل النجاة لخمس سنواتٍ بعد زراعة الكبد يبلغُ ما بين 30-40% في سرطانة الأقنية الصفراوية المحيطة بالنقير،[102] ولكن اعتبر البعض بأنَّ هذا المُعدل قليلٌ جدًا مقارنةً بنقص عينات الكبد المُستعملة في الزراعة، وبالتالي لا يُمكن استعماله كحلٍ علاجي.[103] ولكن رُبما تلعب زراعة الكبد بعد العلاج المساند دورًا في علاج بعض الحالات غير القابلة للجراحة القطعية.[104]
علاجات تجريبية
اقترحت دراسةٌ تجريبية صغيرة وجود فائدةٍ مُحتملة لإرلوتينيب (مثبط لكيناز التيروزين) في الأشخاص المُصابين بمرحلةٍ مُتقدمةٍ من سرطانة الأقنية الصفراوية.[105] كما وُجد أنَّ العلاج الإشعاعي يُطيل من فترة البقاء على قيد الحياة في الأشخاص المُصابين بسرطانة الأقنية الصفراوية خارج الكبد غير القابلة للقطع الجراحي،[106][107] ولكن أظهر العلاج الكيميائي الإشعاعي المُتزامن نتائج تشخيصية أفضل من العلاج الإشعاعي لوحده في حالات سرطانة الأقنية الصفراوية خارج الكبد.[108] لم تُظهر زيادة الجرعة في العلاج الإشعاعي أي نتائج أفضل من الجرعات القياسية المُستعملة في العلاج الإشعاعي لسرطانة الأقنية الصفراوية خارج الكبد، وذلك على عكس سرطانة الأقنية الصفراوية داخل الكبد،[109][110] ورُبما يرجع ذلك إلى قربُ القناة خارج الكبد من الأمعاء، مما يقلل من منطقة الورم التي تُغطيها الجرعة القصوى من الإشعاع.[109]
المآل
يُعتبر القطعُ الجراحي الفرصة الوحيدة المُحتملة للشفاء من سرطانة الأقنية الصفراوية. أما الحالات التي لا يُمكن استعمال القطع الجراحي فيها، فيكون معدل النجاة لخمس سنواتٍ أقل من 5% بشكلٍ عام،[111] و0% إذا بلغ انتشار السرطانة إلى العُقد اللمفاوية البعيدة.[112] بالإجمال، يكون مُتوسط مدة البقاء على قيد الحياة أقل من 6 أشهرٍ في حالة انتشار السرطانة.[113]
تختلف احتماليةُ الشفاء في الحالات القابلة للجراحة اعتمادًا على موقع الورم وفيما إذا كان الورم قد أُزيل كليًا أو جزئيًا. عادةً ما تُعالج سرطانات الأقنية الصفراوية القاصيةُ (تنشأ من القناة الصفراوية المشتركة) جراحيًا بإجراء ويبيل، حيث تتراوح مُعدلات البقاء لأطول مدة ما بين 15-25%، ولكن أشارت دراسةٌ إلى أنَّ معدل النجاة لخمس سنواتٍ يكون 54% في الأشخاص الذين لا يُوجد لديهم انتشارٍ إلى العقد اللمفاوية.[114] أما سرطانات الأقنية الصفراوية داخل الكبد، فعادةً ما تُعالج باستئصال الكبد جزئيًا، وأشارت دراساتٌ مُتعددة أنَّ معدلات البقاء بعد الجراحة تتراوح ما بين 22-66%، كما أنَّ النتائج قد تعتمد على اكتمال العملية الجراحية ومدى انتشار السرطانة إلى العقد اللمفاوية.[115] تُعتبر سرطانات الأقنية الصفراوية المحيطة بالنقير (بالقرب من مخرج الأقنية الصفراوية من الكبد) أقل الأنواع قابليةً للجراحة، وإذا كانت الجراحةُ مُمكنةً، فإنها عمومًا تُعالج بأسلوبٍ شديدٍ يتضمن عادةً استئصال المرارة ورُبما استئصالُ جزءٍ من الكبد، وفي هذه الحالات القابلة للجراحة، يتراوج معدل النجاة لخمس سنواتٍ ما بين 20-50%.[116]
قد يكونُ مآل السرطانة سيئًا في المرضى المُصابين أيضًا بالتهاب الأقنية الصفراوية المصلب الابتدائي، وذلك لأنَّ اكتشاف السرطانة عادةً يكون بعد بلوغها مرحلةً مُتقدمة.[23][117] اقترحت بعض الدراسات أنَّ النتائج الجراحية قد تُصبح أفضل باستعمال أساليبٍ جراحيةٍ شديدة ومعالجةٍ مُساندة.[118] قد تكون هُناك عواملٌ تُدلل على سوء مآل السرطانة القابلة للجراحة، وتتضمن انخفاض مستويات الألبيومين قبل الجراحة، ووجود بقايًا سرطانية (أي أنَّ السرطانة أُزيلت جزئيًا)، بالإضافة إلى مرحلة TNM (مرحلة T، والتي تُعبر عن حجم السرطانة الأساسية).[119] اقتُرح وجود علاقةٍ بين ظهور المستضد CD44 وEpCAM على النسيج الليفي ولُحمَة السرطانة، مع سلامة الآفات المُحيطة بالكبد وخطر تكرار حدوث السرطانة.[120]
الانتشار

تُعتبر سرطانة الأقنية الصفراوية نادرةً نسبيًا، حيثُ تُشخص حوالي 2000 إلى 3000 حالة جديدة سنويًا في الولايات المتحدة، وهذا يُفسر وبائيًا بأنَّ نسبة وقوع سرطانة الأقنية الصفراوية هي 1-2 حالة لكل 100,000 شخص سنويًا.[121] أظهرت سلسلةٌ تشريحية بأنَّ انتشار سرطانة الأقنية الصفراوية ما بين 0.01% إلى 0.46%.[95][122] هناك ارتفاعٌ في معدلاتُ انتشار سرطانة الأقنية الصفراوية في آسيا، ويعود ذلك إلى توطن العداوى الطفيلية المُزمنة هناك. تزداد نسبةُ الإصابة بسرطانة الأقنية الصفراوية مع تقدم العمر، كما يشيعُ حدوث السرطانة في الرجال أكثر من النساء؛ ورُبما ذلك بسبب ارتفاع معدل التهاب الأقنية الصفراوية المصلب الابتدائي في الرجال.[59] حسب دراساتٍ تشريحية، فإنَّ انتشار سرطانة الأقنية الصفراوية في الأشخاص المُصابين بالتهاب الأقنية الصفراوية المصلب الابتدائي قد يصل إلى 30%.[23]
وثقت عدةُ دراساتٍ وجود زيادةٍ ثابتة في معدل حدوث سرطانة الأقنية الصفراوية داخل الكبد على مدى العقود القليلة الماضية، وكانت الزيادة في أمريكا الشمالية وأوروبا وآسيا وأستراليا.[123] ما زالت أسباب زيادة حدوث سرطانة الأقنية الصفراوية غيرُ واضحةٍ، ولكن قد يكون تحُسن طرق التشخيص مسؤولًا بشكلٍ جزئي عن زيادة تشخيص السرطانة، وأيضًا هُناك زيادةٌ في حدوث عوامل الخطر المُحتملة لحدوث السرطانة مثل العدوى بفيروس العوز المناعي البشري.[34]
| الدولة | داخل الكبد (رجال/نساء) | خارج الكبد (رجال/نساء) |
|---|---|---|
| 0.60 / 0.43 | 0.70 / 0.87 | |
| 0.23 / 0.10 | 5.87 / 5.20 | |
| 0.70 / 0.53 | 0.90 / 1.23 | |
| 0.83 / 0.63 | 0.43 / 0.60 | |
| 1.17 / 1.00 | 0.60 / 0.73 | |
| 0.27 / 0.20 | 1.20 / 1.37 | |
| 0.13 / 0.13 | 2.10 / 2.60 |
المراجع
- "NCI Dictionary of Cancer Terms". National Cancer Institute (باللغة الإنجليزية). 2 فبراير 2011. مؤرشف من الأصل في 9 يوليو 2019. اطلع عليه بتاريخ 21 يناير 2019. الوسيط
|CitationClass=تم تجاهله (مساعدة) - Razumilava, N; Gores, GJ (21 يونيو 2014). "Cholangiocarcinoma". Lancet. 383 (9935): 2168–79. doi:10.1016/S0140-6736(13)61903-0. PMC 4069226. PMID 24581682. الوسيط
|CitationClass=تم تجاهله (مساعدة) - "Bile Duct Cancer (Cholangiocarcinoma) Treatment (PDQ®)–Health Professional Version". National Cancer Institute (باللغة الإنجليزية). 14 مارس 2018. مؤرشف من الأصل في 9 يوليو 2019. اطلع عليه بتاريخ 21 يناير 2019. الوسيط
|CitationClass=تم تجاهله (مساعدة) - "Bile Duct Cancer (Cholangiocarcinoma) Symptoms, Tests, Prognosis, and Stages". National Cancer Institute (باللغة الإنجليزية). 5 يوليو 2018. مؤرشف من الأصل في 8 يوليو 2019. اطلع عليه بتاريخ 21 يناير 2019. الوسيط
|CitationClass=تم تجاهله (مساعدة) - Bosman, Frank T. (2014). "Chapter Chapter 5.6: Liver cancer". In Stewart, Bernard W.; Wild, Christopher P (المحررون). World Cancer Report. the International Agency for Research on Cancer, World Health Organization. صفحات Chapter 5.6. ISBN 978-92-832-0443-5. الوسيط
|CitationClass=تم تجاهله (مساعدة)
- Bridgewater, JA; Goodman, KA; Kalyan, A; Mulcahy, MF (2016). "Biliary Tract Cancer: Epidemiology, Radiotherapy, and Molecular Profiling". American Society of Clinical Oncology Educational Book. American Society of Clinical Oncology. Annual Meeting. 35 (36): e194–203. doi:10.1200/EDBK_160831. PMID 27249723. الوسيط
|CitationClass=تم تجاهله (مساعدة) - Benavides, M; Antón, A; Gallego, J; Gómez, MA; Jiménez-Gordo, A; La Casta, A; Laquente, B; Macarulla, T; Rodríguez-Mowbray, JR; Maurel, J (ديسمبر 2015). "Biliary tract cancers: SEOM clinical guidelines". Clinical & Translational Oncology : Official Publication of the Federation of Spanish Oncology Societies and of the National Cancer Institute of Mexico. 17 (12): 982–7. doi:10.1007/s12094-015-1436-2. PMC 4689747. PMID 26607930. الوسيط
|CitationClass=تم تجاهله (مساعدة) - Steele, JA; Richter, CH; Echaubard, P; Saenna, P; Stout, V; Sithithaworn, P; Wilcox, BA (17 مايو 2018). "Thinking beyond Opisthorchis viverrini for risk of cholangiocarcinoma in the lower Mekong region: a systematic review and meta-analysis". Infectious Diseases of Poverty. 7 (1): 44. doi:10.1186/s40249-018-0434-3. PMC 5956617. PMID 29769113. الوسيط
|CitationClass=تم تجاهله (مساعدة) - "World Cholangiocarcinoma Day 2019 CCA: The statistics". worldcholangiocarcinomaday.org. مؤرشف من الأصل في 23 ديسمبر 2018. اطلع عليه بتاريخ 16 يوليو 2019. الوسيط
|CitationClass=تم تجاهله (مساعدة) - "ترجمة (Cholangiocarcinoma) على موقع القاموس". www.alqamoos.org. مؤرشف من الأصل في 26 يناير 2020. اطلع عليه بتاريخ 5 يوليو 2019. الوسيط
|CitationClass=تم تجاهله (مساعدة) - "ترجمة و معنى cholangiocarcinoma بالعربي في قاموس المعاني. قاموس عربي انجليزي مصطلحات صفحة 1". www.almaany.com. مؤرشف من الأصل في 5 يوليو 2019. اطلع عليه بتاريخ 5 يوليو 2019. الوسيط
|CitationClass=تم تجاهله (مساعدة) - "ترجمة (Cholangiocarcinoma) في المعجم الطبي الموحد". ldlp-dictionary.com. مؤرشف من الأصل في 5 يوليو 2019. اطلع عليه بتاريخ 5 يوليو 2019. الوسيط
|CitationClass=تم تجاهله (مساعدة) - احتيوش فرج احتيوش. أسس الجراحة العامة. المكتبة الأكاديمية. صفحة 177. مؤرشف من الأصل في 26 يناير 2020. اطلع عليه بتاريخ 16 يوليو 2019. الوسيط
|CitationClass=تم تجاهله (مساعدة) - "ترجمة (Cholangiocarcinoma) في القاموس الطبي". ldlp-dictionary.com. مؤرشف من الأصل في 5 يوليو 2019. اطلع عليه بتاريخ 5 يوليو 2019. الوسيط
|CitationClass=تم تجاهله (مساعدة) - Lemoine, Nigel Kirkham, Nicholas R. (2001). Progress in pathology. London: Greenwich Medical Media. صفحة 52. ISBN 9781841100500. مؤرشف من الأصل في 8 مايو 2016. الوسيط
|CitationClass=تم تجاهله (مساعدة) - Nagorney DM, Donohue JH, Farnell MB, Schleck CD, Ilstrup DM (أغسطس 1993). "Outcomes after curative resections of cholangiocarcinoma". Archives of Surgery. 128 (8): 871–7, discussion 877–9. doi:10.1001/archsurg.1993.01420200045008. PMID 8393652. الوسيط
|CitationClass=تم تجاهله (مساعدة) - Bile duct cancer: cause and treatment نسخة محفوظة 23 أبريل 2018 على موقع واي باك مشين.
- Nakeeb A, Pitt HA, Sohn TA, Coleman J, Abrams RA, Piantadosi S, Hruban RH, Lillemoe KD, Yeo CJ, Cameron JL (أكتوبر 1996). "Cholangiocarcinoma. A spectrum of intrahepatic, perihilar, and distal tumors". Annals of Surgery. 224 (4): 463–73, discussion 473–5. doi:10.1097/00000658-199610000-00005. PMC 1235406. PMID 8857851. الوسيط
|CitationClass=تم تجاهله (مساعدة) - Mark Feldman; Lawrence S. Friedman; Lawrence J. Brandt, المحررون (21 يوليو 2006). Sleisenger and Fordtran's Gastrointestinal and Liver Disease (الطبعة 8th). Saunders. صفحات 1493–6. ISBN 978-1-4160-0245-1. مؤرشف من الأصل في 26 يناير 2020. الوسيط
|CitationClass=تم تجاهله (مساعدة) - من الدراسات حول استعمال الواسمات المصلية في سرطانة الأقنية الصفراوية (مثل المستضد السرطاني المضغي وCA19-9) في المرضى الذين لا يعانون من التهاب الأقنية الصفراوية المصلب الابتدائي:
- Nehls O, Gregor M, Klump B (مايو 2004). "Serum and bile markers for cholangiocarcinoma". Seminars in Liver Disease. 24 (2): 139–54. doi:10.1055/s-2004-828891. PMID 15192787. الوسيط
|CitationClass=تم تجاهله (مساعدة) - Siqueira E, Schoen RE, Silverman W, Martin J, Rabinovitz M, Weissfeld JL, Abu-Elmaagd K, Madariaga JR, Slivka A, Martini J (يوليو 2002). "Detecting cholangiocarcinoma in patients with primary sclerosing cholangitis". Gastrointestinal Endoscopy. 56 (1): 40–7. doi:10.1067/mge.2002.125105. PMID 12085033. الوسيط
|CitationClass=تم تجاهله (مساعدة) - Levy C, Lymp J, Angulo P, Gores GJ, Larusso N, Lindor KD (سبتمبر 2005). "The value of serum CA 19-9 in predicting cholangiocarcinomas in patients with primary sclerosing cholangitis". Digestive Diseases and Sciences. 50 (9): 1734–40. doi:10.1007/s10620-005-2927-8. PMID 16133981. الوسيط
|CitationClass=تم تجاهله (مساعدة) - Patel AH, Harnois DM, Klee GG, LaRusso NF, Gores GJ (يناير 2000). "The utility of CA 19-9 in the diagnoses of cholangiocarcinoma in patients without primary sclerosing cholangitis". American Journal of Gastroenterology. 95 (1): 204–7. doi:10.1111/j.1572-0241.2000.01685.x. PMID 10638584. الوسيط
|CitationClass=تم تجاهله (مساعدة)
- Nehls O, Gregor M, Klump B (مايو 2004). "Serum and bile markers for cholangiocarcinoma". Seminars in Liver Disease. 24 (2): 139–54. doi:10.1055/s-2004-828891. PMID 15192787. الوسيط
- Chapman RW (1999). "Risk factors for biliary tract carcinogenesis". Annals of Oncology. 10 Suppl 4 (Suppl 4): 308–11. doi:10.1023/A:1008313809752. PMID 10436847. الوسيط
|CitationClass=تم تجاهله (مساعدة) - من الدراسات الوبائية التي أشارت إلى حدوث سرطانة الأقنية الصفراوية في الأشخاص المُصابين بالتهاب الأقنية الصفراوية المصلب الابتدائي (PSC):
- Bergquist A, Ekbom A, Olsson R, Kornfeldt D, Lööf L, Danielsson A, Hultcrantz R, Lindgren S, Prytz H, Sandberg-Gertzén H, Almer S, Granath F, Broomé U (مارس 2002). "Hepatic and extrahepatic malignancies in primary sclerosing cholangitis". Journal of Hepatology. 36 (3): 321–7. doi:10.1016/S0168-8278(01)00288-4. PMID 11867174. الوسيط
|CitationClass=تم تجاهله (مساعدة) - Bergquist A, Glaumann H, Persson B, Broomé U (فبراير 1998). "Risk factors and clinical presentation of hepatobiliary carcinoma in patients with primary sclerosing cholangitis: a case-control study". Hepatology. 27 (2): 311–6. doi:10.1002/hep.510270201. PMID 9462625. الوسيط
|CitationClass=تم تجاهله (مساعدة) - Burak K, Angulo P, Pasha TM, Egan K, Petz J, Lindor KD (مارس 2004). "Incidence and risk factors for cholangiocarcinoma in primary sclerosing cholangitis". American Journal of Gastroenterology. 99 (3): 523–6. doi:10.1111/j.1572-0241.2004.04067.x. PMID 15056096. الوسيط
|CitationClass=تم تجاهله (مساعدة)
- Bergquist A, Ekbom A, Olsson R, Kornfeldt D, Lööf L, Danielsson A, Hultcrantz R, Lindgren S, Prytz H, Sandberg-Gertzén H, Almer S, Granath F, Broomé U (مارس 2002). "Hepatic and extrahepatic malignancies in primary sclerosing cholangitis". Journal of Hepatology. 36 (3): 321–7. doi:10.1016/S0168-8278(01)00288-4. PMID 11867174. الوسيط
- Rosen CB, Nagorney DM, Wiesner RH, Coffey RJ, LaRusso NF (يناير 1991). "Cholangiocarcinoma complicating primary sclerosing cholangitis". Annals of Surgery. 213 (1): 21–5. doi:10.1097/00000658-199101000-00004. PMC 1358305. PMID 1845927. الوسيط
|CitationClass=تم تجاهله (مساعدة) - Watanapa P, Watanapa WB (أغسطس 2002). "Liver fluke-associated cholangiocarcinoma". British Journal of Surgery. 89 (8): 962–70. doi:10.1046/j.1365-2168.2002.02143.x. PMID 12153620. الوسيط
|CitationClass=تم تجاهله (مساعدة) - Sripa B, Kaewkes S, Sithithaworn P, Mairiang E, Laha T, Smout M, Pairojkul C, Bhudhisawasdi V, Tesana S, Thinkamrop B, Bethony JM, Loukas A, Brindley PJ (يوليو 2007). "Liver fluke induces cholangiocarcinoma". PLoS Medicine. 4 (7): e201. doi:10.1371/journal.pmed.0040201. PMC 1913093. PMID 17622191. الوسيط
|CitationClass=تم تجاهله (مساعدة) - Sripa B, Kaewkes S, Intapan PM, Maleewong W, Brindley PJ (2010). Food-borne trematodiases in Southeast Asia epidemiology, pathology, clinical manifestation and control. Advances in Parasitology. 72. صفحات 305–50. doi:10.1016/S0065-308X(10)72011-X. ISBN 9780123815132. PMID 20624536. الوسيط
|CitationClass=تم تجاهله (مساعدة) - Rustagi T, Dasanu CA (يونيو 2012). "Risk factors for gallbladder cancer and cholangiocarcinoma: similarities, differences and updates". Journal of Gastrointestinal Cancer. 43 (2): 137–47. doi:10.1007/s12029-011-9284-y. PMID 21597894. الوسيط
|CitationClass=تم تجاهله (مساعدة) - Hong ST, Fang Y (مارس 2012). "Clonorchis sinensis and clonorchiasis, an update". Parasitology International. 61 (1): 17–24. doi:10.1016/j.parint.2011.06.007. PMID 21741496. الوسيط
|CitationClass=تم تجاهله (مساعدة) - M J S, T L, J M, B S, S S, A J, P J B, A L (2009). "A Granulin-Like Growth Factor Secreted by the Carcinogenic Liver Fluke, Opisthorchis viverrini, Promotes Proliferation of Host Cells". PLoS Pathogens. doi:10.1371/journal.ppat.1000611. مؤرشف من الأصل في 26 يناير 2020. الوسيط
|CitationClass=تم تجاهله (مساعدة); Vancouver style error: punctuation (مساعدة) - Sripa B, Tangkawattana S, Sangnikul T (أغسطس 2017). "The Lawa model: A sustainable, integrated opisthorchiasis control program using the EcoHealth approach in the Lawa Lake region of Thailand". Parasitology International. 66 (4): 346–354. doi:10.1016/j.parint.2016.11.013. PMC 5443708. PMID 27890720. الوسيط
|CitationClass=تم تجاهله (مساعدة) - Kobayashi M, Ikeda K, Saitoh S, Suzuki F, Tsubota A, Suzuki Y, Arase Y, Murashima N, Chayama K, Kumada H (يونيو 2000). "Incidence of primary cholangiocellular carcinoma of the liver in Japanese patients with hepatitis C virus-related cirrhosis". Cancer. 88 (11): 2471–7. doi:10.1002/1097-0142(20000601)88:11<2471::AID-CNCR7>3.0.CO;2-T. PMID 10861422. الوسيط
|CitationClass=تم تجاهله (مساعدة) - Yamamoto S, Kubo S, Hai S, Uenishi T, Yamamoto T, Shuto T, Takemura S, Tanaka H, Yamazaki O, Hirohashi K, Tanaka T (يوليو 2004). "Hepatitis C virus infection as a likely etiology of intrahepatic cholangiocarcinoma". Cancer Science. 95 (7): 592–5. doi:10.1111/j.1349-7006.2004.tb02492.x. PMID 15245596. الوسيط
|CitationClass=تم تجاهله (مساعدة) - Lu H, Ye MQ, Thung SN, Dash S, Gerber MA (ديسمبر 2000). "Detection of hepatitis C virus RNA sequences in cholangiocarcinomas in Chinese and American patients". Chinese Medical Journal. 113 (12): 1138–41. PMID 11776153. الوسيط
|CitationClass=تم تجاهله (مساعدة) - Shaib YH, El-Serag HB, Davila JA, Morgan R, McGlynn KA (مارس 2005). "Risk factors of intrahepatic cholangiocarcinoma in the United States: a case-control study". Gastroenterology. 128 (3): 620–6. doi:10.1053/j.gastro.2004.12.048. PMID 15765398. الوسيط
|CitationClass=تم تجاهله (مساعدة) - Sorensen HT, Friis S, Olsen JH, Thulstrup AM, Mellemkjaer L, Linet M, Trichopoulos D, Vilstrup H, Olsen J (أكتوبر 1998). "Risk of liver and other types of cancer in patients with cirrhosis: a nationwide cohort study in Denmark". Hepatology. 28 (4): 921–5. doi:10.1002/hep.510280404. PMID 9755226. الوسيط
|CitationClass=تم تجاهله (مساعدة) - Chang AH, Parsonnet J (أكتوبر 2010). "Role of bacteria in oncogenesis". Clinical Microbiology Reviews. 23 (4): 837–57. doi:10.1128/CMR.00012-10. PMC 2952975. PMID 20930075. الوسيط
|CitationClass=تم تجاهله (مساعدة) - Lipsett PA, Pitt HA, Colombani PM, Boitnott JK, Cameron JL (نوفمبر 1994). "Choledochal cyst disease. A changing pattern of presentation". Annals of Surgery. 220 (5): 644–52. doi:10.1097/00000658-199411000-00007. PMC 1234452. PMID 7979612. الوسيط
|CitationClass=تم تجاهله (مساعدة) - Dayton MT, Longmire WP, Tompkins RK (يناير 1983). "Caroli's Disease: a premalignant condition?". American Journal of Surgery. 145 (1): 41–8. doi:10.1016/0002-9610(83)90164-2. PMID 6295196. الوسيط
|CitationClass=تم تجاهله (مساعدة) - Mecklin JP, Järvinen HJ, Virolainen M (مارس 1992). "The association between cholangiocarcinoma and hereditary nonpolyposis colorectal carcinoma". Cancer. 69 (5): 1112–4. doi:10.1002/cncr.2820690508. PMID 1310886. الوسيط
|CitationClass=تم تجاهله (مساعدة) - Lee SS, Kim MH, Lee SK, Jang SJ, Song MH, Kim KP, Kim HJ, Seo DW, Song DE, Yu E, Lee SG, Min YI (فبراير 2004). "Clinicopathologic review of 58 patients with biliary papillomatosis". Cancer. 100 (4): 783–93. doi:10.1002/cncr.20031. PMID 14770435. الوسيط
|CitationClass=تم تجاهله (مساعدة) - Lee CC, Wu CY, Chen GH (سبتمبر 2002). "What is the impact of coexistence of hepatolithiasis on cholangiocarcinoma?". Journal of Gastroenterology and Hepatology. 17 (9): 1015–20. doi:10.1046/j.1440-1746.2002.02779.x. PMID 12167124. الوسيط
|CitationClass=تم تجاهله (مساعدة) - Su CH, Shyr YM, Lui WY, P'Eng FK (يوليو 1997). "Hepatolithiasis associated with cholangiocarcinoma". British Journal of Surgery. 84 (7): 969–73. doi:10.1002/bjs.1800840717. PMID 9240138. الوسيط
|CitationClass=تم تجاهله (مساعدة) - Donato F, Gelatti U, Tagger A, Favret M, Ribero ML, Callea F, Martelli C, Savio A, Trevisi P, Nardi G (ديسمبر 2001). "Intrahepatic cholangiocarcinoma and hepatitis C and B virus infection, alcohol intake, and hepatolithiasis: a case-control study in Italy". Cancer Causes & Control. 12 (10): 959–64. doi:10.1023/A:1013747228572. PMID 11808716. الوسيط
|CitationClass=تم تجاهله (مساعدة) - Xavier Causse, « Diagnostic et prise en charge du cholangiocarcinome », paragraphe Étiologie نسخة محفوظة 23 يوليو 2015 على موقع واي باك مشين. [وصلة مكسورة]
- Sahani D, Prasad SR, Tannabe KK, Hahn PF, Mueller PR, Saini S (2003). "Thorotrast-induced cholangiocarcinoma: case report". Abdominal Imaging. 28 (1): 72–4. doi:10.1007/s00261-001-0148-y. PMID 12483389. الوسيط
|CitationClass=تم تجاهله (مساعدة) - Zhu AX, Lauwers GY, Tanabe KK (2004). "Cholangiocarcinoma in association with Thorotrast exposure". Journal of Hepato-Biliary-Pancreatic Surgery. 11 (6): 430–3. doi:10.1007/s00534-004-0924-5. PMID 15619021. الوسيط
|CitationClass=تم تجاهله (مساعدة) - Lipshutz, GS; Brennan, TV; Warren, RS (نوفمبر 2002). "Thorotrast-induced liver neoplasia: a collective review". Journal of the American College of Surgeons. 195 (5): 713–8. doi:10.1016/S1072-7515(02)01287-5. PMID 12437262. الوسيط
|CitationClass=تم تجاهله (مساعدة) - Klatskin G (فبراير 1965). "Adenocarcinoma of the Hepatic Duct at Its Bifurcation Within The Porta Hepatis. An Unusual Tumor With Distinctive Clinical And Pathological Features". American Journal of Medicine. 38 (2): 241–56. doi:10.1016/0002-9343(65)90178-6. PMID 14256720. الوسيط
|CitationClass=تم تجاهله (مساعدة) - Roskams T (يونيو 2006). "Liver stem cells and their implication in hepatocellular and cholangiocarcinoma". Oncogene. 25 (27): 3818–22. doi:10.1038/sj.onc.1209558. PMID 16799623. الوسيط
|CitationClass=تم تجاهله (مساعدة) - Liu C, Wang J, Ou QJ (نوفمبر 2004). "Possible stem cell origin of human cholangiocarcinoma". World Journal of Gastroenterology. 10 (22): 3374–6. doi:10.3748/wjg.v10.i22.3374. PMC 4572317. PMID 15484322. الوسيط
|CitationClass=تم تجاهله (مساعدة) - Sell S, Dunsford HA (يونيو 1989). "Evidence for the stem cell origin of hepatocellular carcinoma and cholangiocarcinoma". American Journal of Pathology. 134 (6): 1347–63. PMC 1879951. PMID 2474256. الوسيط
|CitationClass=تم تجاهله (مساعدة) - Sirica AE (يناير 2005). "Cholangiocarcinoma: molecular targeting strategies for chemoprevention and therapy". Hepatology. 41 (1): 5–15. doi:10.1002/hep.20537. PMID 15690474. الوسيط
|CitationClass=تم تجاهله (مساعدة) - Holzinger F, Z'graggen K, Büchler MW (1999). "Mechanisms of biliary carcinogenesis: a pathogenetic multi-stage cascade towards cholangiocarcinoma". Annals of Oncology. 10 Suppl 4 (Suppl 4): 122–6. doi:10.1023/A:1008321710719. PMID 10436802. الوسيط
|CitationClass=تم تجاهله (مساعدة) - Gores GJ (مايو 2003). "Cholangiocarcinoma: current concepts and insights". Hepatology. 37 (5): 961–9. doi:10.1053/jhep.2003.50200. PMID 12717374. الوسيط
|CitationClass=تم تجاهله (مساعدة) - "2017:Biofilm Producing Salmonella Typhi: Chronic Colonization and Development of Gallbladder Cancer" نسخة محفوظة 26 يناير 2020 على موقع واي باك مشين.
- "2018:The Typhoid Toxin Produced by the Nontyphoidal Salmonella enterica Serotype Javiana Is Required for Induction of a DNA Damage Response In Vitro and Systemic Spread In Vivo" نسخة محفوظة 26 يناير 2020 على موقع واي باك مشين.
- "2017:Biofilm Producing Salmonella Typhi: Chronic Colonization and Development of Gallbladder Cancer" نسخة محفوظة 15 أبريل 2019 على موقع واي باك مشين.
- de Groen PC, Gores GJ, LaRusso NF, Gunderson LL, Nagorney DM (أكتوبر 1999). "Biliary tract cancers". New England Journal of Medicine. 341 (18): 1368–78. doi:10.1056/NEJM199910283411807. PMID 10536130. الوسيط
|CitationClass=تم تجاهله (مساعدة) - Henson DE, Albores-Saavedra J, Corle D (سبتمبر 1992). "Carcinoma of the extrahepatic bile ducts. Histologic types, stage of disease, grade, and survival rates". Cancer. 70 (6): 1498–501. doi:10.1002/1097-0142(19920915)70:6<1498::AID-CNCR2820700609>3.0.CO;2-C. PMID 1516001. الوسيط
|CitationClass=تم تجاهله (مساعدة) - C J S, A J S, A Q N, C B, J S S, T H, R C B, R C S (2006). "Proteomic profiling of cholangiocarcinoma: Diagnostic potential of SELDI-TOF MS in malignant bile duct structure". Hepatology. 44 (3): 658-66. doi:10.1002/hep.21294. الوسيط
|CitationClass=تم تجاهله (مساعدة); Vancouver style error: initials (مساعدة) - Saini S (يونيو 1997). "Imaging of the hepatobiliary tract". New England Journal of Medicine. 336 (26): 1889–94. doi:10.1056/NEJM199706263362607. PMID 9197218. الوسيط
|CitationClass=تم تجاهله (مساعدة) - Sharma MP, Ahuja V (1999). "Aetiological spectrum of obstructive jaundice and diagnostic ability of ultrasonography: a clinician's perspective". Tropical Gastroenterology. 20 (4): 167–9. PMID 10769604. الوسيط
|CitationClass=تم تجاهله (مساعدة) - Bloom CM, Langer B, Wilson SR (1999). "Role of US in the detection, characterization, and staging of cholangiocarcinoma". Radiographics. 19 (5): 1199–218. doi:10.1148/radiographics.19.5.g99se081199. PMID 10489176. الوسيط
|CitationClass=تم تجاهله (مساعدة) - "Youtube, echo-endoscopie" نسخة محفوظة 26 يناير 2020 على موقع واي باك مشين.
- "2005,Place de l'écho-endoscopie dans les maladies de la vésicule biliaire" نسخة محفوظة 15 يوليو 2019 على موقع واي باك مشين.
- Valls C, Gumà A, Puig I, Sanchez A, Andía E, Serrano T, Figueras J (2000). "Intrahepatic peripheral cholangiocarcinoma: CT evaluation". Abdominal Imaging. 25 (5): 490–6. doi:10.1007/s002610000079. PMID 10931983. الوسيط
|CitationClass=تم تجاهله (مساعدة) - Tillich M, Mischinger HJ, Preisegger KH, Rabl H, Szolar DH (سبتمبر 1998). "Multiphasic helical CT in diagnosis and staging of hilar cholangiocarcinoma". AJR. American Journal of Roentgenology. 171 (3): 651–8. doi:10.2214/ajr.171.3.9725291. PMID 9725291. الوسيط
|CitationClass=تم تجاهله (مساعدة) - Zhang Y, Uchida M, Abe T, Nishimura H, Hayabuchi N, Nakashima Y (1999). "Intrahepatic peripheral cholangiocarcinoma: comparison of dynamic CT and dynamic MRI". Journal of Computer Assisted Tomography. 23 (5): 670–7. doi:10.1097/00004728-199909000-00004. PMID 10524843. الوسيط
|CitationClass=تم تجاهله (مساعدة) - Akamatsu, Sugawara (2010). "Diagnostic accuracy of multidetector-row computed tomography for hilar cholangiocarcinoma". Hepatology. doi:10.1111/j.1440-1746.2009.06113.x. الوسيط
|CitationClass=تم تجاهله (مساعدة) - Sugiyama M, Hagi H, Atomi Y, Saito M (1997). "Diagnosis of portal venous invasion by pancreatobiliary carcinoma: value of endoscopic ultrasonography". Abdominal Imaging. 22 (4): 434–8. doi:10.1007/s002619900227. PMID 9157867. الوسيط
|CitationClass=تم تجاهله (مساعدة) - Schwartz LH, Coakley FV, Sun Y, Blumgart LH, Fong Y, Panicek DM (يونيو 1998). "Neoplastic pancreaticobiliary duct obstruction: evaluation with breath-hold MR cholangiopancreatography". AJR. American Journal of Roentgenology. 170 (6): 1491–5. doi:10.2214/ajr.170.6.9609160. PMID 9609160. الوسيط
|CitationClass=تم تجاهله (مساعدة) - Zidi SH, Prat F, Le Guen O, Rondeau Y, Pelletier G (يناير 2000). "Performance characteristics of magnetic resonance cholangiography in the staging of malignant hilar strictures". Gut. 46 (1): 103–6. doi:10.1136/gut.46.1.103. PMC 1727781. PMID 10601064. الوسيط
|CitationClass=تم تجاهله (مساعدة) - Lee MG, Park KB, Shin YM, Yoon HK, Sung KB, Kim MH, Lee SG, Kang EM (مارس 2003). "Preoperative evaluation of hilar cholangiocarcinoma with contrast-enhanced three-dimensional fast imaging with steady-state precession magnetic resonance angiography: comparison with intraarterial digital subtraction angiography". World Journal of Surgery. 27 (3): 278–83. doi:10.1007/s00268-002-6701-1. PMID 12607051. الوسيط
|CitationClass=تم تجاهله (مساعدة) - Yeh TS, Jan YY, Tseng JH, Chiu CT, Chen TC, Hwang TL, Chen MF (فبراير 2000). "Malignant perihilar biliary obstruction: magnetic resonance cholangiopancreatographic findings". American Journal of Gastroenterology. 95 (2): 432–40. doi:10.1111/j.1572-0241.2000.01763.x. PMID 10685746. الوسيط
|CitationClass=تم تجاهله (مساعدة) - Freeman ML, Sielaff TD (2003). "A modern approach to malignant hilar biliary obstruction". Reviews in Gastroenterological Disorders. 3 (4): 187–201. PMID 14668691. الوسيط
|CitationClass=تم تجاهله (مساعدة) - Szklaruk J, Tamm E, Charnsangavej C (أكتوبر 2002). "Preoperative imaging of biliary tract cancers". Surgical Oncology Clinics of North America. 11 (4): 865–76. doi:10.1016/S1055-3207(02)00032-7. PMID 12607576. الوسيط
|CitationClass=تم تجاهله (مساعدة) - Weber SM, DeMatteo RP, Fong Y, Blumgart LH, Jarnagin WR (مارس 2002). "Staging laparoscopy in patients with extrahepatic biliary carcinoma. Analysis of 100 patients". Annals of Surgery. 235 (3): 392–9. doi:10.1097/00000658-200203000-00011. PMC 1422445. PMID 11882761. الوسيط
|CitationClass=تم تجاهله (مساعدة) - Callery MP, Strasberg SM, Doherty GM, Soper NJ, Norton JA (يوليو 1997). "Staging laparoscopy with laparoscopic ultrasonography: optimizing resectability in hepatobiliary and pancreatic malignancy". Journal of the American College of Surgeons. 185 (1): 33–9. doi:10.1016/s1072-7515(97)00003-3. PMID 9208958. الوسيط
|CitationClass=تم تجاهله (مساعدة) - Länger F, von Wasielewski R, Kreipe HH (يوليو 2006). "[The importance of immunohistochemistry for the diagnosis of cholangiocarcinomas]". Der Pathologe (باللغة الألمانية). 27 (4): 244–50. doi:10.1007/s00292-006-0836-z. PMID 16758167. الوسيط
|CitationClass=تم تجاهله (مساعدة) - Darwin PE, Kennedy A. Cholangiocarcinoma في موقع إي ميديسين
- Patsenker, Wilkens, Banz, Österreicher, Weimann, Eisele, Keogh, Stroka, Zimmermann, Stickel (2010). "The αvβ6 integrin is a highly specific immunohistochemical marker for cholangiocarcinoma". Journal of Hepatology. doi:10.1016/j.jhep.2009.12.006. الوسيط
|CitationClass=تم تجاهله (مساعدة) - Zervos EE, Osborne D, Goldin SB, Villadolid DV, Thometz DP, Durkin A, Carey LC, Rosemurgy AS (نوفمبر 2005). "Stage does not predict survival after resection of hilar cholangiocarcinomas promoting an aggressive operative approach". American Journal of Surgery. 190 (5): 810–5. doi:10.1016/j.amjsurg.2005.07.025. PMID 16226963. الوسيط
|CitationClass=تم تجاهله (مساعدة) - Tsao JI, Nimura Y, Kamiya J, Hayakawa N, Kondo S, Nagino M, Miyachi M, Kanai M, Uesaka K, Oda K, Rossi RL, Braasch JW, Dugan JM (أغسطس 2000). "Management of hilar cholangiocarcinoma: comparison of an American and a Japanese experience". Annals of Surgery. 232 (2): 166–74. doi:10.1097/00000658-200008000-00003. PMC 1421125. PMID 10903592. الوسيط
|CitationClass=تم تجاهله (مساعدة) - Rajagopalan V, Daines WP, Grossbard ML, Kozuch P (يونيو 2004). "Gallbladder and biliary tract carcinoma: A comprehensive update, Part 1". Oncology. 18 (7): 889–96. PMID 15255172. الوسيط
|CitationClass=تم تجاهله (مساعدة) - Chirurgie radicale des cholangiocarcinomes périphériques نسخة محفوظة 15 يوليو 2019 على موقع واي باك مشين.
- Cholangiocarcinome périphérique, voir le tableau au paragraphe Résultats, par Yves-Patrice Le Treut. نسخة محفوظة 13 مارس 2016 على موقع واي باك مشين.
- Su CH, Tsay SH, Wu CC, Shyr YM, King KL, Lee CH, Lui WY, Liu TJ, P'eng FK (أبريل 1996). "Factors influencing postoperative morbidity, mortality, and survival after resection for hilar cholangiocarcinoma". Annals of Surgery. 223 (4): 384–94. doi:10.1097/00000658-199604000-00007. PMC 1235134. PMID 8633917. الوسيط
|CitationClass=تم تجاهله (مساعدة) - Rosen CB, Heimbach JK, Gores GJ (2008). "Surgery for cholangiocarcinoma: the role of liver transplantation". HPB. 10 (3): 186–9. doi:10.1080/13651820801992542. PMC 2504373. PMID 18773052. الوسيط
|CitationClass=تم تجاهله (مساعدة) - Todoroki T, Ohara K, Kawamoto T, Koike N, Yoshida S, Kashiwagi H, Otsuka M, Fukao K (فبراير 2000). "Benefits of adjuvant radiotherapy after radical resection of locally advanced main hepatic duct carcinoma". International Journal of Radiation Oncology, Biology, Physics. 46 (3): 581–7. doi:10.1016/S0360-3016(99)00472-1. PMID 10701737. الوسيط
|CitationClass=تم تجاهله (مساعدة) - Alden ME, Mohiuddin M (مارس 1994). "The impact of radiation dose in combined external beam and intraluminal Ir-192 brachytherapy for bile duct cancer". International Journal of Radiation Oncology, Biology, Physics. 28 (4): 945–51. doi:10.1016/0360-3016(94)90115-5. PMID 8138448. الوسيط
|CitationClass=تم تجاهله (مساعدة) - González González D, Gouma DJ, Rauws EA, van Gulik TM, Bosma A, Koedooder C (1999). "Role of radiotherapy, in particular intraluminal brachytherapy, in the treatment of proximal bile duct carcinoma". Annals of Oncology. 10 Suppl 4 (Suppl 4): 215–20. doi:10.1023/A:1008339709327. PMID 10436826. الوسيط
|CitationClass=تم تجاهله (مساعدة) - Pitt HA, Nakeeb A, Abrams RA, Coleman J, Piantadosi S, Yeo CJ, Lillemore KD, Cameron JL (يونيو 1995). "Perihilar cholangiocarcinoma. Postoperative radiotherapy does not improve survival". Annals of Surgery. 221 (6): 788–97, discussion 797–8. doi:10.1097/00000658-199506000-00017. PMC 1234714. PMID 7794082. الوسيط
|CitationClass=تم تجاهله (مساعدة) - Takada T, Amano H, Yasuda H, Nimura Y, Matsushiro T, Kato H, Nagakawa T, Nakayama T (أكتوبر 2002). "Is postoperative adjuvant chemotherapy useful for gallbladder carcinoma? A phase III multicenter prospective randomized controlled trial in patients with resected pancreaticobiliary carcinoma". Cancer. 95 (8): 1685–95. doi:10.1002/cncr.10831. PMID 12365016. الوسيط
|CitationClass=تم تجاهله (مساعدة) - "National Comprehensive Cancer Network (NCCN) guidelines on evaluation and treatment of hepatobiliary malignancies" (PDF). مؤرشف من الأصل (PDF) في 26 مارس 2009. الوسيط
|CitationClass=تم تجاهله (مساعدة) (216 KB). Retrieved 13 March 2007. - Vauthey JN, Blumgart LH (مايو 1994). "Recent advances in the management of cholangiocarcinomas". Seminars in Liver Disease. 14 (2): 109–14. doi:10.1055/s-2007-1007302. PMID 8047893. الوسيط
|CitationClass=تم تجاهله (مساعدة) - Glimelius B, Hoffman K, Sjödén PO, Jacobsson G, Sellström H, Enander LK, Linné T, Svensson C (أغسطس 1996). "Chemotherapy improves survival and quality of life in advanced pancreatic and biliary cancer". Annals of Oncology. 7 (6): 593–600. doi:10.1093/oxfordjournals.annonc.a010676. PMID 8879373. الوسيط
|CitationClass=تم تجاهله (مساعدة) - Choi CW, Choi IK, Seo JH, Kim BS, Kim JS, Kim CD, Um SH, Kim JS, Kim YH (أغسطس 2000). "Effects of 5-fluorouracil and leucovorin in the treatment of pancreatic-biliary tract adenocarcinomas". American Journal of Clinical Oncology. 23 (4): 425–8. doi:10.1097/00000421-200008000-00023. PMID 10955877. الوسيط
|CitationClass=تم تجاهله (مساعدة) - Park JS, Oh SY, Kim SH, Kwon HC, Kim JS, Jin-Kim H, Kim YH (فبراير 2005). "Single-agent gemcitabine in the treatment of advanced biliary tract cancers: a phase II study". Japanese Journal of Clinical Oncology. 35 (2): 68–73. doi:10.1093/jjco/hyi021. PMID 15709089. الوسيط
|CitationClass=تم تجاهله (مساعدة) - Giuliani F, Gebbia V, Maiello E, Borsellino N, Bajardi E, Colucci G (يونيو 2006). "Gemcitabine and cisplatin for inoperable and/or metastatic biliary tree carcinomas: a multicenter phase II study of the Gruppo Oncologico dell'Italia Meridionale (GOIM)". Annals of Oncology. 17 Suppl 7 (Suppl 7): vii73–7. doi:10.1093/annonc/mdl956. PMID 16760299. الوسيط
|CitationClass=تم تجاهله (مساعدة) - Bhargava P, Jani CR, Savarese DM, O'Donnell JL, Stuart KE, Rocha Lima CM (سبتمبر 2003). "Gemcitabine and irinotecan in locally advanced or metastatic biliary cancer: preliminary report". Oncology. 17 (9 Suppl 8): 23–6. PMID 14569844. الوسيط
|CitationClass=تم تجاهله (مساعدة) - Knox JJ, Hedley D, Oza A, Feld R, Siu LL, Chen E, Nematollahi M, Pond GR, Zhang J, Moore MJ (أبريل 2005). "Combining gemcitabine and capecitabine in patients with advanced biliary cancer: a phase II trial". Journal of Clinical Oncology. 23 (10): 2332–8. doi:10.1200/JCO.2005.51.008. PMID 15800324. الوسيط
|CitationClass=تم تجاهله (مساعدة) - بي دي إف Traitement chirurgical du cholangiocarcinome du hile نسخة محفوظة 7 مايو 2020 على موقع واي باك مشين.
- بي دي إف Traitement chirurgical du cholangiocarcinome périphérique نسخة محفوظة 7 مايو 2020 على موقع واي باك مشين. [وصلة مكسورة]
- Heimbach JK, Gores GJ, Haddock MG, Alberts SR, Pedersen R, Kremers W, Nyberg SL, Ishitani MB, Rosen CB (ديسمبر 2006). "Predictors of disease recurrence following neoadjuvant chemoradiotherapy and liver transplantation for unresectable perihilar cholangiocarcinoma". Transplantation. 82 (12): 1703–7. doi:10.1097/01.tp.0000253551.43583.d1. PMID 17198263. مؤرشف من الأصل في 22 مايو 2013. الوسيط
|CitationClass=تم تجاهله (مساعدة) - Philip PA, Mahoney MR, Allmer C, Thomas J, Pitot HC, Kim G, Donehower RC, Fitch T, Picus J, Erlichman C (يوليو 2006). "Phase II study of erlotinib in patients with advanced biliary cancer". Journal of Clinical Oncology. 24 (19): 3069–74. doi:10.1200/JCO.2005.05.3579. PMID 16809731. الوسيط
|CitationClass=تم تجاهله (مساعدة) - Shinohara ET, Mitra N, Guo M, Metz JM (يوليو 2009). "Radiotherapy is associated with improved survival in adjuvant and palliative treatment of extrahepatic cholangiocarcinomas". International Journal of Radiation Oncology, Biology, Physics. 74 (4): 1191–8. doi:10.1016/j.ijrobp.2008.09.017. PMID 19201549. الوسيط
|CitationClass=تم تجاهله (مساعدة) - Brunner TB, Schwab D, Meyer T, Sauer R (ديسمبر 2004). "Chemoradiation may prolong survival of patients with non-bulky unresectable extrahepatic biliary carcinoma. A retrospective analysis". Strahlentherapie Und Onkologie : Organ Der Deutschen Rontgengesellschaft... [Et Al]. 180 (12): 751–7. doi:10.1007/s00066-004-1315-1. PMID 15592694. الوسيط
|CitationClass=تم تجاهله (مساعدة) - Torgeson A, Lloyd S, Boothe D, Cannon G, Garrido-Laguna I, Whisenant J, Lewis M, Kim R, Scaife C, Tao R (ديسمبر 2017). "Chemoradiation Therapy for Unresected Extrahepatic Cholangiocarcinoma: A Propensity Score-Matched Analysis". Annals of Surgical Oncology. 24 (13): 4001–4008. doi:10.1245/s10434-017-6131-9. PMID 29043526. الوسيط
|CitationClass=تم تجاهله (مساعدة) - Elganainy D, Holliday EB, Taniguchi CM, Smith GL, Shroff R, Javle M, Raghav K, Kaseb A, Aloia TA, Vauthey JN, Tzeng CD, Herman JM, Koong AC, Krishnan SX, Minsky BD, Crane CH, Das P, Koay EJ (أغسطس 2018). "Dose escalation of radiotherapy in unresectable extrahepatic cholangiocarcinoma". Cancer Medicine. 7 (10): 4880–4892. doi:10.1002/cam4.1734. PMC 6198206. PMID 30152073. الوسيط
|CitationClass=تم تجاهله (مساعدة) - Tao R, Krishnan S, Bhosale PR, Javle MM, Aloia TA, Shroff RT, Kaseb AO, Bishop AJ, Swanick CW, Koay EJ, Thames HD, Hong TS, Das P, Crane CH (يناير 2016). "Ablative Radiotherapy Doses Lead to a Substantial Prolongation of Survival in Patients With Inoperable Intrahepatic Cholangiocarcinoma: A Retrospective Dose Response Analysis". Journal of Clinical Oncology. 34 (3): 219–26. doi:10.1200/JCO.2015.61.3778. PMC 4980564. PMID 26503201. الوسيط
|CitationClass=تم تجاهله (مساعدة) - Farley DR, Weaver AL, Nagorney DM (مايو 1995). "'Natural history' of unresected cholangiocarcinoma: patient outcome after noncurative intervention". Mayo Clinic Proceedings. 70 (5): 425–9. doi:10.4065/70.5.425. PMID 7537346. الوسيط
|CitationClass=تم تجاهله (مساعدة) - Yamamoto M, Takasaki K, Yoshikawa T (مارس 1999). "Lymph node metastasis in intrahepatic cholangiocarcinoma". Japanese Journal of Clinical Oncology. 29 (3): 147–50. doi:10.1093/jjco/29.3.147. PMID 10225697. الوسيط
|CitationClass=تم تجاهله (مساعدة) - Grove MK, Hermann RE, Vogt DP, Broughan TA (أبريل 1991). "Role of radiation after operative palliation in cancer of the proximal bile ducts". American Journal of Surgery. 161 (4): 454–8. doi:10.1016/0002-9610(91)91111-U. PMID 1709795. الوسيط
|CitationClass=تم تجاهله (مساعدة) - دراساتٌ حول النتائج الجراحية في سرطانة الأقنية الصفراوية القاصية:
- Nakeeb A, Pitt HA, Sohn TA, Coleman J, Abrams RA, Piantadosi S, Hruban RH, Lillemoe KD, Yeo CJ, Cameron JL (أكتوبر 1996). "Cholangiocarcinoma. A spectrum of intrahepatic, perihilar, and distal tumors". Annals of Surgery. 224 (4): 463–73, discussion 473–5. doi:10.1097/00000658-199610000-00005. PMC 1235406. PMID 8857851. الوسيط
|CitationClass=تم تجاهله (مساعدة) - Jang JY, Kim SW, Park DJ, Ahn YJ, Yoon YS, Choi MG, Suh KS, Lee KU, Park YH (يناير 2005). "Actual long-term outcome of extrahepatic bile duct cancer after surgical resection". Annals of Surgery. 241 (1): 77–84. doi:10.1097/01.sla.0000150166.94732.88 (غير نشط 2019-06-14). PMC 1356849. PMID 15621994. الوسيط
|CitationClass=تم تجاهله (مساعدة) - Bortolasi L, Burgart LJ, Tsiotos GG, Luque-De León E, Sarr MG (2000). "Adenocarcinoma of the distal bile duct. A clinicopathologic outcome analysis after curative resection". Digestive Surgery. 17 (1): 36–41. doi:10.1159/000018798. PMID 10720830. الوسيط
|CitationClass=تم تجاهله (مساعدة) - Fong Y, Blumgart LH, Lin E, Fortner JG, Brennan MF (ديسمبر 1996). "Outcome of treatment for distal bile duct cancer". British Journal of Surgery. 83 (12): 1712–5. doi:10.1002/bjs.1800831217. PMID 9038548. الوسيط
|CitationClass=تم تجاهله (مساعدة)
- Nakeeb A, Pitt HA, Sohn TA, Coleman J, Abrams RA, Piantadosi S, Hruban RH, Lillemoe KD, Yeo CJ, Cameron JL (أكتوبر 1996). "Cholangiocarcinoma. A spectrum of intrahepatic, perihilar, and distal tumors". Annals of Surgery. 224 (4): 463–73, discussion 473–5. doi:10.1097/00000658-199610000-00005. PMC 1235406. PMID 8857851. الوسيط
- دراساتٌ حول النتائج الجراحية في سرطانة الأقنية الصفراوية داخل الكبد:
- Nakeeb A, Pitt HA, Sohn TA, Coleman J, Abrams RA, Piantadosi S, Hruban RH, Lillemoe KD, Yeo CJ, Cameron JL (أكتوبر 1996). "Cholangiocarcinoma. A spectrum of intrahepatic, perihilar, and distal tumors". Annals of Surgery. 224 (4): 463–73, discussion 473–5. doi:10.1097/00000658-199610000-00005. PMC 1235406. PMID 8857851. الوسيط
|CitationClass=تم تجاهله (مساعدة) - Lieser MJ, Barry MK, Rowland C, Ilstrup DM, Nagorney DM (1998). "Surgical management of intrahepatic cholangiocarcinoma: a 31-year experience". Journal of Hepato-Biliary-Pancreatic Surgery. 5 (1): 41–7. doi:10.1007/PL00009949. PMID 9683753. الوسيط
|CitationClass=تم تجاهله (مساعدة) - Valverde A, Bonhomme N, Farges O, Sauvanet A, Flejou JF, Belghiti J (1999). "Resection of intrahepatic cholangiocarcinoma: a Western experience". Journal of Hepato-Biliary-Pancreatic Surgery. 6 (2): 122–7. doi:10.1007/s005340050094. PMID 10398898. الوسيط
|CitationClass=تم تجاهله (مساعدة) - Nakagohri T, Asano T, Kinoshita H, Kenmochi T, Urashima T, Miura F, Ochiai T (مارس 2003). "Aggressive surgical resection for hilar-invasive and peripheral intrahepatic cholangiocarcinoma". World Journal of Surgery. 27 (3): 289–93. doi:10.1007/s00268-002-6696-7. PMID 12607053. الوسيط
|CitationClass=تم تجاهله (مساعدة) - Weber SM, Jarnagin WR, Klimstra D, DeMatteo RP, Fong Y, Blumgart LH (أكتوبر 2001). "Intrahepatic cholangiocarcinoma: resectability, recurrence pattern, and outcomes". Journal of the American College of Surgeons. 193 (4): 384–91. doi:10.1016/S1072-7515(01)01016-X. PMID 11584966. الوسيط
|CitationClass=تم تجاهله (مساعدة)
- Nakeeb A, Pitt HA, Sohn TA, Coleman J, Abrams RA, Piantadosi S, Hruban RH, Lillemoe KD, Yeo CJ, Cameron JL (أكتوبر 1996). "Cholangiocarcinoma. A spectrum of intrahepatic, perihilar, and distal tumors". Annals of Surgery. 224 (4): 463–73, discussion 473–5. doi:10.1097/00000658-199610000-00005. PMC 1235406. PMID 8857851. الوسيط
- تقديراتُ البقاء على قيد الحياة بعد جراحة سرطانة الأقنية الصفراوية المحيطة بالنقيل:
- Burke EC, Jarnagin WR, Hochwald SN, Pisters PW, Fong Y, Blumgart LH (سبتمبر 1998). "Hilar Cholangiocarcinoma: patterns of spread, the importance of hepatic resection for curative operation, and a presurgical clinical staging system". Annals of Surgery. 228 (3): 385–94. doi:10.1097/00000658-199809000-00011. PMC 1191497. PMID 9742921. الوسيط
|CitationClass=تم تجاهله (مساعدة) - Tsao JI, Nimura Y, Kamiya J, Hayakawa N, Kondo S, Nagino M, Miyachi M, Kanai M, Uesaka K, Oda K, Rossi RL, Braasch JW, Dugan JM (أغسطس 2000). "Management of hilar cholangiocarcinoma: comparison of an American and a Japanese experience". Annals of Surgery. 232 (2): 166–74. doi:10.1097/00000658-200008000-00003. PMC 1421125. PMID 10903592. الوسيط
|CitationClass=تم تجاهله (مساعدة) - Chamberlain RS, Blumgart LH (2000). "Hilar cholangiocarcinoma: a review and commentary". Annals of Surgical Oncology. 7 (1): 55–66. doi:10.1007/s10434-000-0055-4. PMID 10674450. الوسيط
|CitationClass=تم تجاهله (مساعدة) - Washburn WK, Lewis WD, Jenkins RL (مارس 1995). "Aggressive surgical resection for cholangiocarcinoma". Archives of Surgery. 130 (3): 270–6. doi:10.1001/archsurg.1995.01430030040006. PMID 7534059. الوسيط
|CitationClass=تم تجاهله (مساعدة) - Nagino M, Nimura Y, Kamiya J, Kanai M, Uesaka K, Hayakawa N, Yamamoto H, Kondo S, Nishio H (1998). "Segmental liver resections for hilar cholangiocarcinoma". Hepato-Gastroenterology. 45 (19): 7–13. PMID 9496478. الوسيط
|CitationClass=تم تجاهله (مساعدة) - Rea DJ, Munoz-Juarez M, Farnell MB, Donohue JH, Que FG, Crownhart B, Larson D, Nagorney DM (مايو 2004). "Major hepatic resection for hilar cholangiocarcinoma: analysis of 46 patients". Archives of Surgery. 139 (5): 514–23, discussion 523–5. doi:10.1001/archsurg.139.5.514. PMID 15136352. الوسيط
|CitationClass=تم تجاهله (مساعدة) - Launois B, Reding R, Lebeau G, Buard JL (2000). "Surgery for hilar cholangiocarcinoma: French experience in a collective survey of 552 extrahepatic bile duct cancers". Journal of Hepato-Biliary-Pancreatic Surgery. 7 (2): 128–34. doi:10.1007/s005340050166. PMID 10982604. الوسيط
|CitationClass=تم تجاهله (مساعدة)
- Burke EC, Jarnagin WR, Hochwald SN, Pisters PW, Fong Y, Blumgart LH (سبتمبر 1998). "Hilar Cholangiocarcinoma: patterns of spread, the importance of hepatic resection for curative operation, and a presurgical clinical staging system". Annals of Surgery. 228 (3): 385–94. doi:10.1097/00000658-199809000-00011. PMC 1191497. PMID 9742921. الوسيط
- Kaya M, de Groen PC, Angulo P, Nagorney DM, Gunderson LL, Gores GJ, Haddock MG, Lindor KD (أبريل 2001). "Treatment of cholangiocarcinoma complicating primary sclerosing cholangitis: the Mayo Clinic experience". American Journal of Gastroenterology. 96 (4): 1164–9. doi:10.1111/j.1572-0241.2001.03696.x. PMID 11316165. الوسيط
|CitationClass=تم تجاهله (مساعدة) - Nakeeb A, Tran KQ, Black MJ, Erickson BA, Ritch PS, Quebbeman EJ, Wilson SD, Demeure MJ, Rilling WS, Dua KS, Pitt HA (أكتوبر 2002). "Improved survival in resected biliary malignancies". Surgery. 132 (4): 555–63, discission 563–4. doi:10.1067/msy.2002.127555. PMID 12407338. الوسيط
|CitationClass=تم تجاهله (مساعدة) - Ramacciato G (2006). "Facteurs pronostiques après résection pour cholangiocarcinome hilaire". Annales de Chirurgie. 131 (6–7): 379-85. doi:10.1016/j.anchir.2006.03.006. الوسيط
|CitationClass=تم تجاهله (مساعدة) - Sulpice, L. (2014). Rôle du microenvironnement dans la progression du cholangiocarcinome intrahépatique: mécanismes moléculaires impliqués et recherche de biomarqueurs pronostiques (Doctoral dissertation, Rennes 1).
- Landis SH, Murray T, Bolden S, Wingo PA (1998). "Cancer statistics, 1998". Ca. 48 (1): 6–29. doi:10.3322/canjclin.48.1.6. PMID 9449931. الوسيط
|CitationClass=تم تجاهله (مساعدة) - Cancer Statistics Home Page — National Cancer Institute نسخة محفوظة 29 أبريل 2015 على موقع واي باك مشين.
- وثقت عدة دراساتٌ مستقلة بوجود زيادةٍ ثابتة في معدل حدوث سرطانة الأقنية الصفراوية في العالم. بعض المقالات المُتعلقة:
- Patel T (مايو 2002). "Worldwide trends in mortality from biliary tract malignancies". BMC Cancer. 2: 10. doi:10.1186/1471-2407-2-10. PMC 113759. PMID 11991810. الوسيط
|CitationClass=تم تجاهله (مساعدة) - Patel T (يونيو 2001). "Increasing incidence and mortality of primary intrahepatic cholangiocarcinoma in the United States". Hepatology. 33 (6): 1353–7. doi:10.1053/jhep.2001.25087. PMID 11391522. الوسيط
|CitationClass=تم تجاهله (مساعدة) - Shaib YH, Davila JA, McGlynn K, El-Serag HB (مارس 2004). "Rising incidence of intrahepatic cholangiocarcinoma in the United States: a true increase?". Journal of Hepatology. 40 (3): 472–7. doi:10.1016/j.jhep.2003.11.030. PMID 15123362. الوسيط
|CitationClass=تم تجاهله (مساعدة) - West J, Wood H, Logan RF, Quinn M, Aithal GP (يونيو 2006). "Trends in the incidence of primary liver and biliary tract cancers in England and Wales 1971-2001". British Journal of Cancer. 94 (11): 1751–8. doi:10.1038/sj.bjc.6603127. PMC 2361300. PMID 16736026. الوسيط
|CitationClass=تم تجاهله (مساعدة) - Khan SA, Taylor-Robinson SD, Toledano MB, Beck A, Elliott P, Thomas HC (ديسمبر 2002). "Changing international trends in mortality rates for liver, biliary and pancreatic tumours". Journal of Hepatology. 37 (6): 806–13. doi:10.1016/S0168-8278(02)00297-0. PMID 12445422. الوسيط
|CitationClass=تم تجاهله (مساعدة) - Welzel TM, McGlynn KA, Hsing AW, O'Brien TR, Pfeiffer RM (يونيو 2006). "Impact of classification of hilar cholangiocarcinomas (Klatskin tumors) on the incidence of intra- and extrahepatic cholangiocarcinoma in the United States". Journal of the National Cancer Institute. 98 (12): 873–5. doi:10.1093/jnci/djj234. PMID 16788161. الوسيط
|CitationClass=تم تجاهله (مساعدة)
- Patel T (مايو 2002). "Worldwide trends in mortality from biliary tract malignancies". BMC Cancer. 2: 10. doi:10.1186/1471-2407-2-10. PMC 113759. PMID 11991810. الوسيط
- Khan SA, Taylor-Robinson SD, Toledano MB, Beck A, Elliott P, Thomas HC (ديسمبر 2002). "Changing international trends in mortality rates for liver, biliary and pancreatic tumours". Journal of Hepatology. 37 (6): 806–13. doi:10.1016/S0168-8278(02)00297-0. PMID 12445422. الوسيط
|CitationClass=تم تجاهله (مساعدة)
روابط خارجية
- الدليل المفصل حول سرطانة الأقنية الصفراوية لجمعية السرطان الأمريكية.
- معلومات المريض حول أورام الأقنية الصفراوية خارج الكبد من المعهد الوطني للسرطان.
- Cancer.Net: سرطانة الأقنية الصفراوية
- يوم سرطانة الأقنية الصفراوية العالمي 2018
- بوابة طب